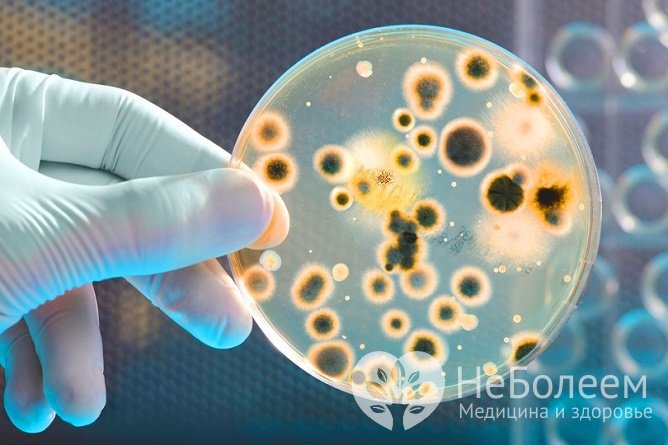
Основной метод диагностики кишечных инфекций – бактериологическое исследование

Воспользуйтесь поиском по сайту:
Кишечная инфекция
Содержание статьи:
Кишечные инфекции – это большая группа инфекционных заболеваний бактериальной и вирусной природы, протекающие с интоксикацией, кишечным синдромом и дегидратацией. В структуре инфекционной заболеваемости кишечные инфекции занимают второе место, уступая по частоте только острым респираторным вирусным инфекциям. Они значительно чаще поражают детей, чем взрослых. Особенно опасны кишечные инфекции для детей первых лет жизни.
 Источник: ogemorroe.com
Источник: ogemorroe.comПричины и факторы риска
Возбудителями кишечной инфекции могут выступать разные патогенные микроорганизмы – бактерии, простейшие, грибы и вирусы. Чаще всего развитие заболевания вызывают:
- грамотрицательные энтеробактерии (иерсинии, эшерихии, кампилобактеры, сальмонеллы, шигеллы);
- условно-патогенные бактерии (стафилококки, протей, клостридии, клебсиелы);
- вирусы (аденовирусы, энтеровирусы, ротавирусы);
- простейшие (кокцидии, амебы, лямблии);
- грибы.
Все возбудители кишечных инфекций обладают энтеропатогенностью и способностью к синтезу экзо- и эндотоксинов.
Основой профилактики кишечных инфекций является соблюдение санитарно-гигиенических норм.
Источником инфекции являются больные с явной или стертой клинической картиной заболевания, носители, некоторые виды домашних животных. Заражение происходит по фекально-оральному механизму водным, алиментарным (через пищу), контактно-бытовым (через предметы обихода, игрушки, грязные руки, посуду) путями.
Причиной развития кишечной инфекции, вызванной условно-патогенной флорой, является резкое ослабление защитных сил организма, которое может быть вызвано разными причинами. В результате этого нарушается нормальный биоценоз кишечника, что сопровождается уменьшением количества нормальной микрофлоры и увеличением условно-патогенной.
Немаловажную роль в развитии кишечной инфекции играют нарушения правил приготовления и хранения пищи, допуск к работе на пищеблоках сотрудников со стрептодермией, фурункулезом, тонзиллитом и другими инфекционными заболеваниями.
Инфекции, передающиеся водным и пищевым путем, способны поражать большие группы населения, вызывая эпидемические вспышки, но значительно чаще регистрируются единичные (спорадические) случаи.
Заболеваемость некоторыми видами кишечных инфекций имеет явно выраженную сезонную зависимость, например, ротавирусный гастроэнтерит чаще регистрируется в зимние месяцы, а дизентерия – летом.
Предрасполагающими к инфицированию факторами являются:
- несоблюдение правил личной гигиены;
- низкая кислотность желудочного сока;
- плохие санитарно-гигиенические условия проживания;
- отсутствие доступа к качественной питьевой воде;
- дисбактериоз кишечника.
Формы заболевания
Классификация кишечной инфекции проводится по клинико-этиологическому принципу. Наиболее часто в клинической практике наблюдаются:
- ротавирусная инфекция;
- дизентерия (шигеллез);
- эшерихиоз (коли-инфекция);
- сальмонеллез;
- стафилококковая инфекция.
В зависимости от особенностей симптоматики (интоксикация, нарушения водно-электролитного баланса, поражение органов желудочно-кишечного тракта) течение кишечной инфекции может быть атипичным (гипертоксическим, стертым) или типичным (тяжелое, средней тяжести, легкое).
Выраженное обезвоживание организма может привести к развитию гиповолемического шока, острой почечной недостаточности.
Местные проявления кишечных инфекций определяются тем, какой именно орган пищеварительной системы оказывается в наибольшей степени втянутым в патологический процесс. В связи с этим выделяют гастриты, гастроэнтериты, гастродуодениты, дуодениты, энтериты, колиты и энтероколиты.
У ослабленных пациентов кишечная инфекция способна распространиться за пределы желудочно-кишечного тракта и привести к поражению других органов и систем. В этом случае говорят о генерализации инфекционного процесса.
По длительности течения:
- острая кишечная инфекция – менее 6 недель;
- затяжная – свыше 6 недель;
- хроническая – заболевание длится свыше 6 месяцев.
Симптомы кишечной инфекции
Кишечная инфекция, вне зависимости от вида возбудителя, проявляется симптомами интоксикации и поражения желудочно-кишечного тракта. Однако некоторые виды заболевания имеют характерные симптомы.
Дизентерия
Инкубационный период продолжается от 1 до 7 дней. Заболевание начинается остро с озноба и быстрого повышения температуры до 39-40 °С. На высоте лихорадки у больного могут возникнуть бред, нарушения сознания, судороги. Другие симптомы:
- разбитость;
- резкая слабость;
- отсутствие или значительное снижение аппетита;
- головная боль;
- миалгия;
- схваткообразные боли в животе, локализующиеся в левой подвздошной области;
- спазм и болезненность сигмовидной кишки;
- тенезмы (ложные позывы на дефекацию);
- признаки сфинктерита;
- дефекация от 4 до 20 раз за сутки.
Каловые массы жидкие, содержат примесь крови и слизи. При тяжелом течении инфекционного процесса развивается геморрагический синдром, проявляющийся кишечным кровотечением.
Наиболее тяжелое течение свойственно дизентерии, вызванной шигеллами Григорьева – Шига или Флекснера.
Сальмонеллез
В 90% случаев сальмонеллез протекает по типу гастрита, гастроэнтерита или гастроэнтероколита. Характерно подострое начало – поднимается температура до 38-39 °С, возникают тошнота, рвота.
В остром периоде заболевания назначается водно-чайная пауза длительностью 1-2 суток.
В некоторых случаях увеличивается печень и селезенка (гепатоспленомегалия). Стул частый и обильный, каловые массы приобретают цвет болотной тины, содержат незначительные примеси крови и слизи. Этот вид кишечной инфекции у взрослых обычно заканчивается выздоровлением, а у детей может принимать жизнеугрожающий характер из-за быстро развивающегося обезвоживания.
 Источник: vancomycin.ru
Источник: vancomycin.ruРеспираторная (гриппоподобная) форма сальмонеллезной инфекции наблюдается у 4-5% пациентов. Ее основные симптомы:
- фебрильная температура;
- головная боль;
- артралгия, миалгия;
- конъюнктивит;
- ринит;
- фарингит;
- артериальная гипотония;
- тахикардия.
Тифоподобная форма сальмонеллеза наблюдается крайне редко (не более 2% от всех случаев). Для нее характерен длительный период лихорадки (до 1–1,5 месяцев), нарушения функций сердечно-сосудистой системы и выраженная общая интоксикация.
Септическая форма сальмонеллеза в основном диагностируется у детей первых месяцев жизни или у взрослых пациентов с резко ослабленным иммунитетом (ВИЧ-инфекция, тяжело протекающие сопутствующие заболевания). Протекает крайне тяжело. Сопровождается септикопиемией или септицемией, нарушением метаболизма, развитием тяжелых осложнений (паренхиматозный гепатит, пневмония, менингит, отоантрит, остеомиелит).
Эшерихиозы
Самая обширная группа кишечных инфекций. Она объединяет коли-инфекции, вызванные энтерогеморрагическими, энтероинвазными, энтеротоксигенными и энтеропатогенными эшерихиями.
Основными симптомами эшерихиоза являются:
- субфебрильная или фебрильная температура тела;
- вялость, слабость;
- упорная рвота (у грудных детей – частые срыгивания);
- снижение аппетита;
- метеоризм.
Стул частый, обильный водянистый, желтоватого цвета. Если заболевание вызвано энтерогеморрагическими эшерихиями, то каловые массы содержат примесь крови.
Заболеваемость некоторыми видами кишечных инфекций имеет явно выраженную сезонную зависимость, например, ротавирусный гастроэнтерит чаще регистрируется в зимние месяцы, а дизентерия – летом.
Повторная рвота и выраженная диарея быстро приводят к дегидратации, развитию эксикоза. Отмечается сухость слизистых оболочек и кожных покровов, эластичность и тургор тканей снижается, уменьшается количество отделяемой мочи.
Ротавирусная инфекция
Ротавирусная кишечная инфекция в большинстве случаев протекает по типу энтерита или гастроэнтерита. Длительность инкубационного периода в среднем составляет 1–3 дня. Заболевание начинается остро, его симптомы достигают максимальной выраженности уже к концу первых суток. Одним из основных признаков этой формы является сочетание поражения органов желудочно-кишечного тракта с катаральными явлениями.
У пациентов отмечаются:
- признаки общей интоксикации;
- повышение температуры тела;
- тошнота, рвота;
- диарея с частотой дефекации от 4 до 15 раз в сутки (стул пенистый, водянистый);
- респираторный синдром (першение в горле, ринит, гиперемия зева, покашливание).
Длительность заболевания обычно не превышает 4–7 суток.
Стафилококковая кишечная инфекция
В зависимости от механизма заражения стафилококковая кишечная инфекция бывает двух видов:
- первичная – возбудитель попадает в желудочно-кишечный тракт водным или алиментарным путем из окружающей среды;
- вторичная – стафилококки заносятся в пищеварительную систему с током крови из каких-либо других очагов первичной инфекции в организме.
Стафилококковая кишечная инфекция протекает достаточно тяжело, сопровождается развитием тяжелого токсикоза и эксикоза. Стул водянистый, частый, 10–15 раз в сутки. Имеет зеленоватый цвет и может содержать небольшую примесь слизи.
У ослабленных пациентов кишечная инфекция способна распространиться за пределы желудочно-кишечного тракта и привести к поражению других органов и систем.
Вторичная стафилококковая кишечная инфекция у взрослых наблюдается крайне редко. Чаще всего она развивается у детей как осложнение острого тонзиллита, стафилодермии, пневмонии, пиелонефрита и других заболеваний, вызванных стафилококками. Для этой формы характерно длительное волнообразное течение.
Читайте также:7 положительных привычек, которые могут нанести вред здоровью
5 причин для отказа от антибактериальных средств личной гигиены
Диагностика
На основании клинических и эпидемиологических данных, результатов физикального осмотра пациента можно поставить диагноз кишечной инфекции и в некоторых случаях даже предположить ее вид. Однако установление точной этиологической причины заболевания возможно только на основании результатов лабораторных исследований.
Наибольшее диагностическое значение имеет бактериологическое исследование каловых масс. Материал для исследования следует забирать с первых часов заболевания, до начала терапии антибактериальными препаратами. При развитии генерализованной формы кишечной инфекции выполняют бактериологическое исследование крови (посев на стерильность), мочи, ликвора.
Источник: shostka.info
Источник: shostka.infoОпределенную ценность в диагностике кишечных инфекций представляют серологические методы исследования (РСК, ИФА, РПГА). Они позволяют выявить наличие в сыворотке крови антител к возбудителям кишечной инфекции и таким образом идентифицировать их.
Для уточнения локализации патологического процесса в желудочно-кишечном тракте назначается копрограмма.
Дифференциальная диагностика проводится с дискинезией желчевыводящих путей, лактазной недостаточностью, панкреатитом, острым аппендицитом и другой патологией со схожими симптомами. При наличии показаний пациента консультируют хирург, гастроэнтеролог.
Местные проявления кишечных инфекций определяются тем, какой именно орган пищеварительной системы оказывается в наибольшей степени втянутым в патологический процесс.
Лечение кишечной инфекции
Схема лечения кишечной инфекции включает следующие направления:
- оральная регидратация;
- лечебное питание;
- патогенетическая терапия – коррекция имеющихся нарушений функций внутренних органов, повышение иммунной реактивности и неспецифической резистентности организма, нормализация обмена веществ;
- этиотропная терапия – устранение причины, вызвавшей развитие заболевание;
- симптоматическая терапия – устранение симптомов патологического процесса.
С целью коррекции нарушений водно-электролитного баланса проводится оральная регидратация (порошок ВОЗ, Регидрон, Педитрал). Глюкозо-солевые растворы следует пить часто, маленькими глотками – это позволяет предотвратить появление или возобновление рвоты. При тяжелом состоянии пациента, когда он не может принимать жидкость внутрь, проводят инфузионную терапию растворами электролитов и глюкозы.
Специфическая терапия кишечных инфекций проводится кишечными антисептиками и антибиотиками (Налидиксовая кислота, Фуразолидон, Полимиксин, Гентамицин, Канамицин), энтеросорбентами (Активированный уголь, Фильтрум СТИ, Смекта). При наличии показаний назначают иммуноглобулины (антистафилококковый, антиротавирусный), лактоглобулины и бактериофаги (клебсиеллезный, колипротейный, дизентерийный, сальмонеллезный и другие).
Патогенетическое лечение кишечных инфекций предполагает назначение антигистаминных препаратов и ферментов.
При повышенной температуре тела показаны нестероидные противовоспалительные средства. Спастические боли в животе купируют приемом спазмолитиков.
В структуре инфекционной заболеваемости кишечные инфекции занимают второе место, уступая по частоте только острым респираторным вирусным инфекциям.
В остром периоде заболевания назначается водно-чайная пауза длительностью 1-2 суток. Диета пациентов с кишечными инфекциями направлена на улучшение процессов пищеварения, обеспечение механического, термического и химического щажения слизистой оболочки желудочно-кишечного тракта. Пищу следует принимать часто небольшими порциями. После стихания острых явлений в рацион вводят кисели, некрепкие бульоны с белыми сухариками, хорошо разваренный рис, картофельное пюре, паровые тефтели.
Возможные последствия и осложнения
Выраженное обезвоживание организма может привести к развитию гиповолемического шока, острой почечной недостаточности. Не мене опасна генерализация патологического процесса, которая может осложниться инфекционно-токсическим шоком, сепсисом, ДВС-синдромом, отеком легких, острой сердечно-сосудистой недостаточностью.
Прогноз
В целом прогноз при кишечной инфекции благоприятный. Он ухудшается при заболевании детей первых лет жизни, лиц с иммунодефицитными состояниями и страдающих тяжелой сопутствующей патологией, а также при несвоевременном начале лечения.
Профилактика кишечных инфекций
Основой профилактики кишечных инфекций является соблюдение санитарно-гигиенических норм.
Особенно важно:
- тщательное мытье рук после посещения туалета и перед едой;
- соблюдение правил приготовления и хранения продуктов питания;
- отказ от употребления воды из непроверенных источников;
- тщательное мытье перед употреблением овощей и фруктов;
- изоляция больных кишечными инфекциями;
- проведение в очаге инфекции текущей и заключительной дезинфекции.
Источники
- Плоскирева А.А. Острые кишечные инфекции в педиатрической практике. 2016. Медицинская сестра.
- Тикунова Нина Викторовна, Жираковская Елена Владимировна Вирусы — возбудители кишечных инфекций. 2012. Наука из первых рук;
- Халявина А. А., Савиных М. В. Эпидемиология острых кишечных инфекций. 2009. Вятский медицинский вестник;
- Бондаренко Алла Львовна, Любезнова Ольга Николаевна, Попонин Михаил Васильевич, Глушкова Татьяна Владимировна, Яковлева Ирина Александровна, и др. Дифференциальная диагностика острых кишечных инфекций. 2011. Вятский медицинский вестник;
- Никонорова Марина Анатольевна, Салдан Игорь Петрович, Карбышева Нина Валентиновна, Пак Сергей Григорьевич, Белая Ольга Федоровна, и др. Острые кишечные инфекции в амбулаторной практике. 2018. Эпидемиология и инфекционные болезни.
- Н. Е. Филичкина, Н. А. Шибеко, И. В. Ряжечкина, Н. В. Хамцов Эпидемиология острых кишечных инфекций. 2005. Вестник Смоленской государственной медицинской академии.
Видео с YouTube по теме статьи:
Об авторе

Диплом по специальности «Педиатрия», Санкт-Петербургский государственный педиатрический медицинский университет
Интернатура по специальности «Эндокринология», Кировская государственная медицинская академия
Информация является обобщенной и предоставляется в ознакомительных целях. При первых признаках болезни обратитесь к врачу. Самолечение опасно для здоровья!
74-летний житель Австралии Джеймс Харрисон становился донором крови около 1000 раз. У него редкая группа крови, антитела которой помогают выжить новорожденным с тяжелой формой анемии. Таким образом, австралиец спас около двух миллионов детей.


























